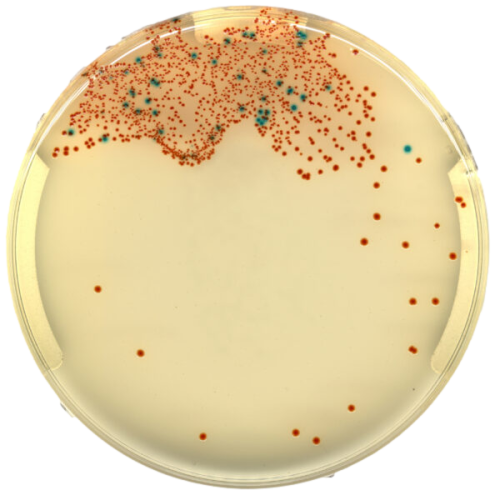
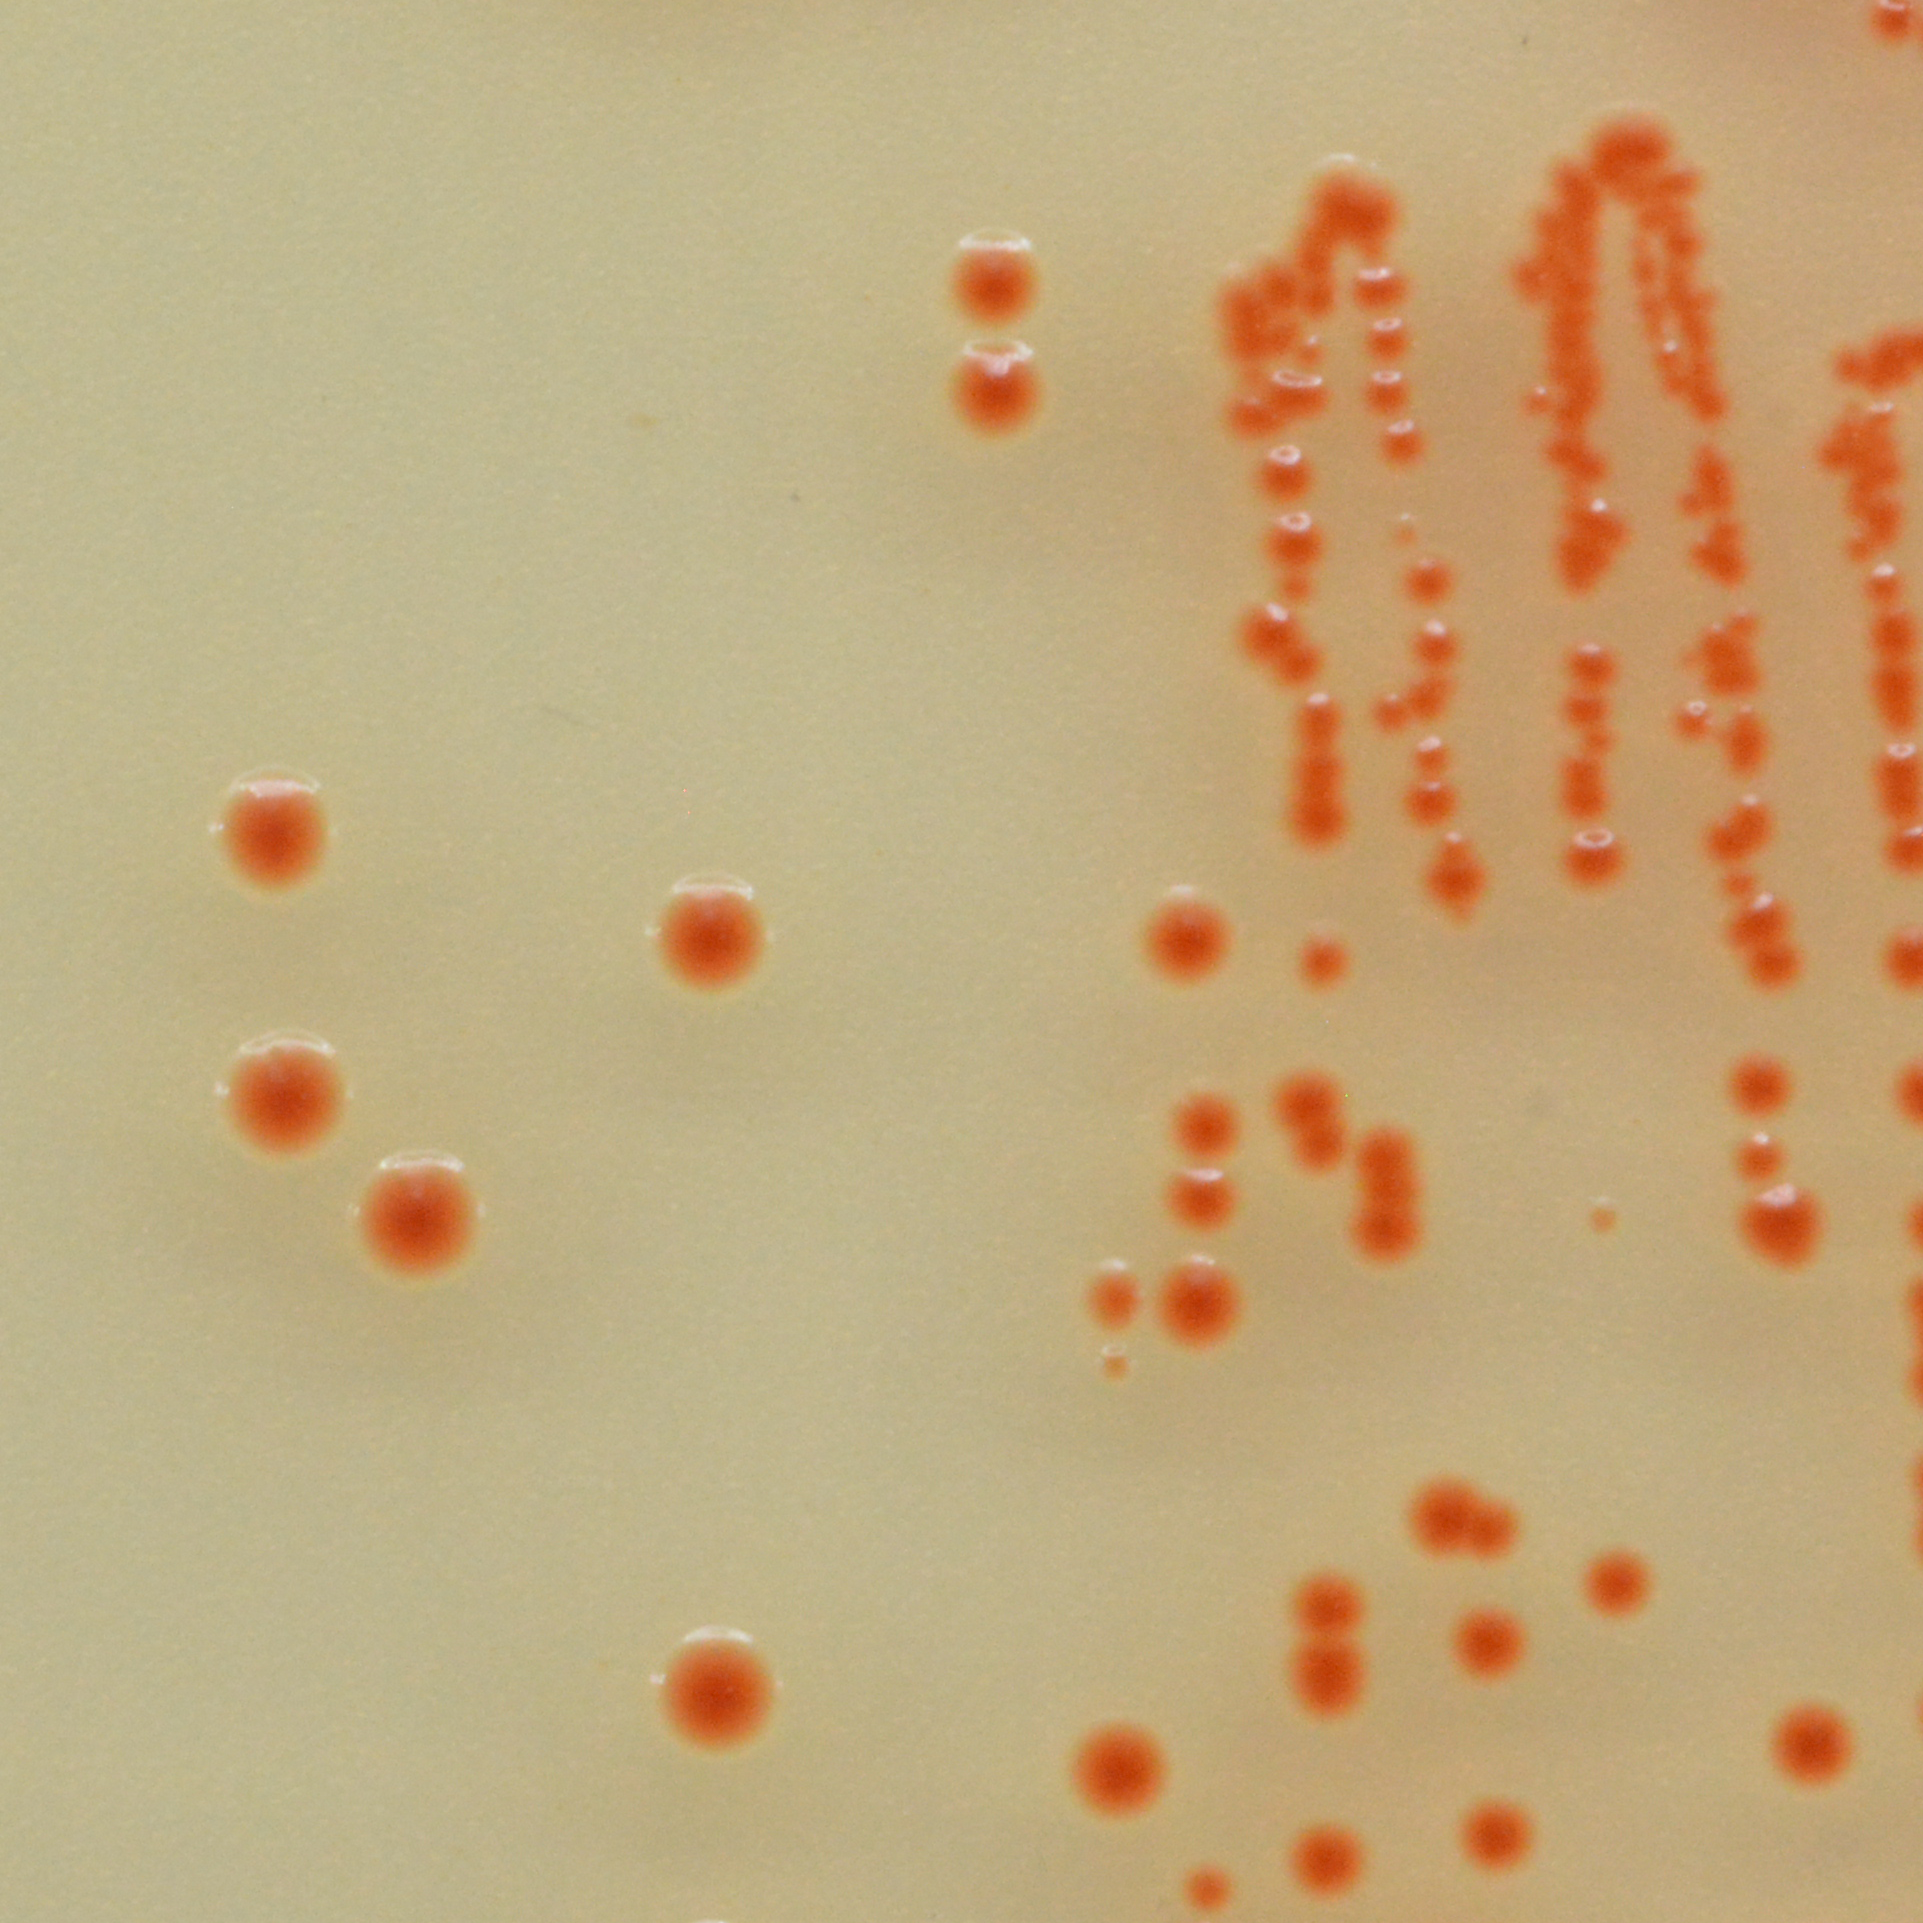

CHROMagar™ StrepA
Để sàng lọc Streptococci nhóm A trong mẫu dịch họng.
Thông tin đặt hàng
– SP372…………5000mL
Bao gồm: Base SP372(B) + supplement SP372(S1) + SP372(S2)
– SP373-25…………25L
Bao gồm: Base SP373-25(B) + supplement SP373-25(S1) + SP373-25(S2)


KHUẨN LẠC ĐIỂN HÌNH
Streptococci nhóm A
Màu cam đến màu hồng

Streptococci khác
Không màu hoặc màu xanh
Hiệu NĂNG
Streptococcus pyogenes (GAS) gây viêm họng ở trẻ em và những đối tượng khác. Khoảng 15 triệu lượt tư vấn mỗi năm ở Hoa Kỳ (Shulman và cộng sự, 2012). Nguyên nhân phổ biến nhất gây viêm họng cấp vẫn là do virus.
GAS chỉ ảnh hưởng đến 20-30% ở trẻ em và 5-15% ở người lớn, điều trị bằng kháng sinh là cần thiết để tránh nhiều biến chứng xâm lấn và bệnh lý miễn dịch. Quyết định điều trị thường phải được đưa ra bởi phòng tư vấn. Đã có nhiều hình thức lâm sàng được phát hiện, nhưng thường không thể phân biệt được nguyên nhân Streptococcus chỉ dựa trên các triệu chứng lâm sàng.
Vì lý do này, các phương pháp chẩn đoán đã được phát triển bao gồm các xét nghiệm có thể được thực hiện trong quá trình tư vấn hoặc quyết định của bác sĩ: Xét nghiệm kháng nguyên, xét nghiệm phân tử và nuôi cấy trên môi trường thạch máu, là Tiêu chuẩn Vàng. Chỉ nuôi cấy mới cho phép thực hiện kháng sinh đồ và theo dõi dịch tễ học của các chủng.
Mục đích sử dụng
CHROMagar™ StrepA là môi trường sinh màu nuôi cấy chọn lọc nhằm sử dụng để phát hiện định tính trực tiếp, phân biệt và nhận diện Streptococcus pyogenes -Streptococcus nhóm A (GAS) để hỗ trợ chẩn đoán nhiễm trùng họng do GAS. Xét nghiệm được thực hiện bằng tăm bông lấy dịch họng. Kết quả có thể được giải thích sau 18-24 giờ ủ ở 35-37°C trong môi trường có CO2 .
Nuôi cấy đồng loạt là cần thiết phục hồi các sinh vật để thử nghiệm vi sinh hoặc phân loại dịch tễ học. Việc thiếu sự phát triển hoặc không có khuẩn lạc trên CHROMagar™ StrepA không loại trừ sự hiện diện của GAS CHROMagar™ StrepA. Sản phẩm này không nhằm mục đích chẩn đoán nhiễm trùng cũng như hướng dẫn hay theo dõi việc điều trị các bệnh nhiễm trùng.
1. Môi trường sinh màu đầu tiên: được dùng để phát hiện S. pyogenes.
Thành phần

tài liệu kỹ thuật
công bố khoa học
2019
Xác nhận và triển khai thạch Colorex™ CHROMagar™ Strep A trên WASP™/WASPLab™ để sàng lọc Streptococcus pyogenes bằng ESwab™
2019
Phát hiện kỹ thuật số và sử dụng Trí tuệ nhân tạo để phát hiện Streptococcus Nhóm A bằng môi trường thạch tạo màu
2019
Tự động phát hiện các thế hệ Streptococcus Viêm họng bằng cách sử dụng Phần mềm mô-đun phát hiện nhiễm sắc thể trí tuệ nhân tạo Colorex Strep A CHROMagar và WASPLab